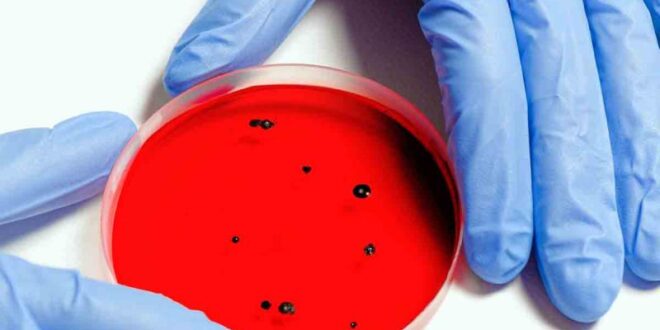

La OMS “recomendó encarecidamente al Ministerio de Sanidad ucraniano y a otras agencias responsables que destruya los patógenos muy peligrosos para impedir que se propaguen por accidente”
La Organización Mundial de la Salud (OMS) instó “encarecidamente” a Ucrania a deshacerse de posibles “patógenos muy peligrosos” en sus laboratorios para evitar cualquier riesgo de contagio entre la población, debido a la guerra que afecta a una parte del país.
La OMS “recomendó encarecidamente al Ministerio de Sanidad ucraniano y a otras agencias responsables que destruya los patógenos muy peligrosos para impedir que se propaguen por accidente”, indicó este viernes la agencia de la ONU.
Consciente de la preocupación que esta recomendación -revelada por la agencia Reuters- puede crear tras las amenazas a las centrales nucleares, la organización la ha situado en el contexto más amplio de su cooperación de muchos años con las autoridades ucranianas para mejorar la seguridad en esas instalaciones.
La OMS, en sus recomendaciones generales sobre la seguridad en los laboratorios “siempre insiste en un enfoque basado en la evaluación de los riesgos”, destacó Tarik Jasarevic, portavoz de la institución internacional que vela por la salud mundial, en una rueda de prensa en Ginebra.
Los laboratorios siempre deberían tener en cuenta la situación en la que se encuentran y asegurar que, en caso de amenaza, haya una forma de eliminar, con toda seguridad, los patógenos presentes normalmente en todos los países por razones de salud pública y así evitar un escape accidental”, precisó Jasarevic.
Interrogado por la AFP, la OMS descartó ofrecer una lista de centros de investigación en Ucrania ni indicó su nivel de seguridad, ni los gérmenes a los que se refiere.
Jasarevic tampoco dijo si un laboratorio afectado por estas recomendaciones se localizaba en una de las áreas que están siendo bombardeadas y ocupadas por el ejército ruso. Información Excelsior.com.mx
 Yucatán al Instante Noticias al Instante
Yucatán al Instante Noticias al Instante